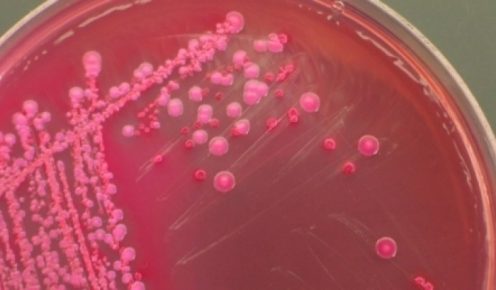

Pana acum credeam ca baia este incaperea din casa unde intalnim cei mai multi microbi, dar lucrurile nu stau chiar asa. Un studiu recent publicat de topinspired.com atesta faptul ca bucataria este locul unde se gasesc cei mai periculosi microbi.
Iata locurile pe care trebuie sa le dezinfectezi cel mai des si obiectele pe care trebuie sa le schimbi periodic:
- Chiuveta – acesta este locul cel mai murdar din toata bucataria. Aici se gasesc microbi precum salmonella sau E-coli, care ajung in chiuveta dupa ce speli legumele, fructele si carnea. Mediul fiind umed, mediul este mai mult decat prielnic pentru a se inmulti in voie, iar locul poate deveni un adevarat focar de infectie. Pentru a preveni acest lucru este indicat sa dezinfectezi chiuveta la 2- 3 zile si nu uiti nici de marginile sale si de robineti.
- Buretele de spalat vasele – multi considera ca acesta este curat pentru ca este tot timpul spalat cu detergentul de vase. Ei bine, lucrurile nu stau chiar asa. Printre porii acestuia este mediu extrem de prielnic pentru bacterii sa se inmulteasca si sa se dezvolte in voie. E-coli este una dintre aceste bacterii, care este si foarte periculoasa pentru oameni. Este indicat ca acesta sa fie schimbat la maxim o luna si sa fie pus in cuprotul cu microunde la cateva zile pentru 2 minute la temperatura ridicata. Aceasta omoara microbii si impiedica dezvoltarea acestora.
- Pare un loc curat, insa si aici intalnim aceleasi bacterii. Este locul unui pui pungile cand te intorci de la cumparaturi, unde pui legumele si fructele dupa ce le-ai cumparat, dar si alte alimente. Din aceasta cauza pe blat se aduna o multime de bacterii daunatoare organismului uman. Dezinfecteaza blatul macar o data la 2 zile pentru a te feri de bacterii si microbi.
loading...
Loading...